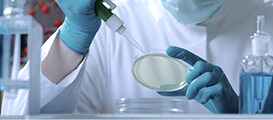
Thermo Scientific Microbiology

Thermo Scientific
Thermo Scientific offers customers a complete range of high-end analytical instruments as well as laboratory equipment, software, services, consumables and reagents to enable integrated laboratory workflow solutions.
Thermo Scientific analytical instruments help tackle tough analytical challenges using advanced technologies ranging from mass spectrometry and elemental analysis to chromatography, molecular spectroscopy and microanalysis.
Life science research consumables provide essential lab supplies, bioreagents, sera, antibodies and kits as well as a variety of other consumables.
A comprehensive range of laboratory equipment includes centrifuges, incubators, ULT freezers, electrochemistry meters, electrophoresis, constant-temperature and water purification equipment.